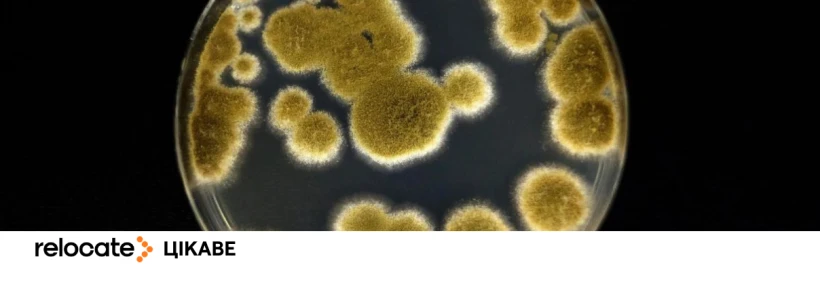
Вчені знайшли плісняву, здатну вижити на Марсі

Топ запитів українців

Рішення прем'єр-міністра Іспанії Педро Санчеса надати легальний...Читати далі
Не зупиняйся! Читай більше корисних постів в розділіСтатті

relocate
Слідкую
Читачі
NaN
Дописи
Відповіді
favorite_border
0
visibility1
more_vert

З 1 травня 2026 року на двох вокзалах Берліна діятиме повна...Читати далі
Німеччина
favorite_border
0
visibility1
more_vert

Переїзд у 2026 році вже не схожий на історію про омріяний...Читати далі
favorite_border
0
visibility102
more_vert

Уряд Ірландії ухвалив рішення щодо поступового згортання...Читати далі
favorite_border
0
visibility1
more_vert

У Латвії офіційно дозволили обмін українських водійських...Читати далі
Латвія
favorite_border
0
visibility2
more_vert
Деякі земні організми можуть бути стійкішими, ніж очікувалося....Читати далі
favorite_border
0
visibility1
more_vert

Ірландія готується поступово згортати частину програм підтримки...Читати далі
favorite_border
0
visibility9
more_vert

Sony Pictures презентувала міжнародний трейлер нового...Читати далі
favorite_border
0
visibility2
more_vert

Дедалі більше молодих чоловіків Німеччини подають заяви про...Читати далі
favorite_border
0
visibility3
more_vert

Кількість іноземців, які отримали дозволи на проживання у...Читати далі
Польща
favorite_border
0
visibility5
more_vert

У Польщі готуються до запуску нового етапу легалізації для...Читати далі
favorite_border
0
visibility179
more_vert

- Навігація
- Підписатись на новини
- Юридична інформація
- Про проєкт
- Контакти
- Політика конфіденційності
- Користувацька угода
- Зв'яжіться з нами!
Ви можете написати нам безпосередньо на з вашого улюбленого поштового клієнта, або за допомогою форми зворотного зв'язку.
Зв'язатися з командою Relocate